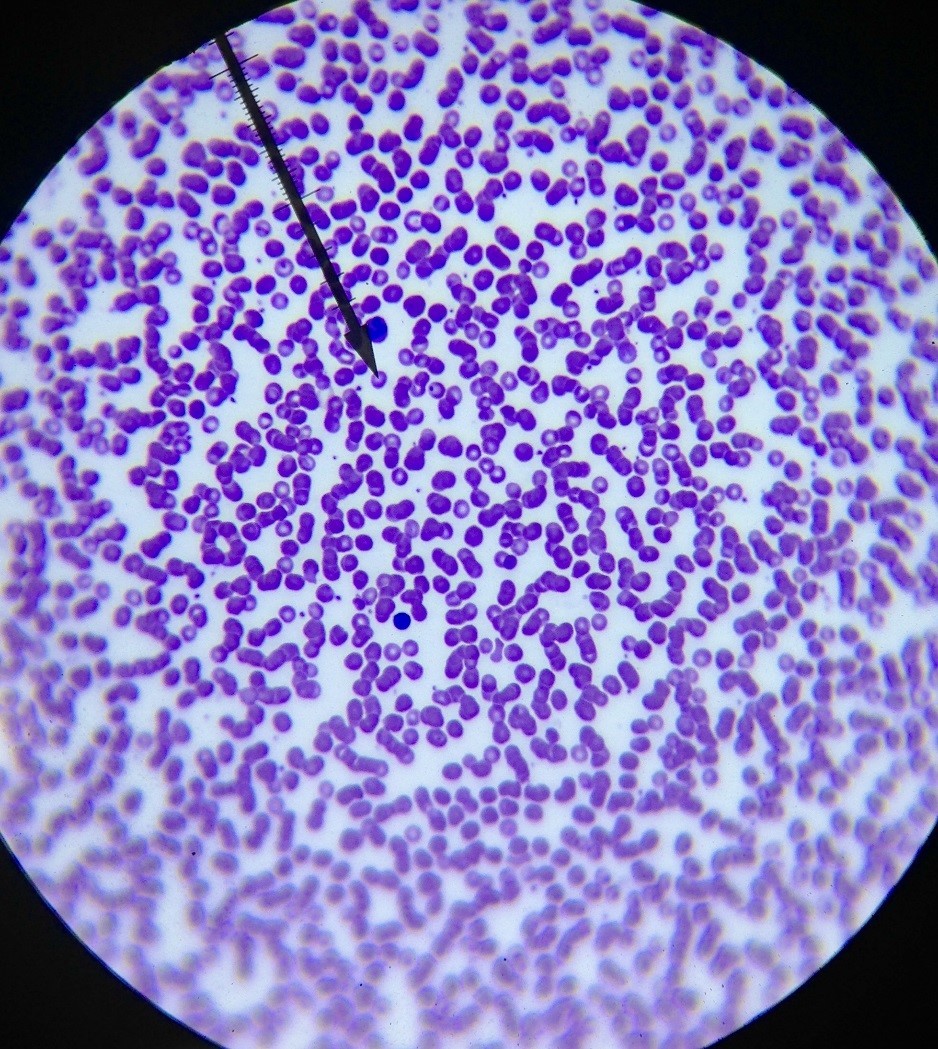

Simple Squamous Epithelium
Lungs, Cappillaries, Kidneys

Simple Cuboidal Epithelium
Kidneys, Ovaries

Simple Columnar Epithelium
Intestines

Pseudostratified Columnar Epithelium
Trachea, Fallopian tubes
+Cilia
+Goblet Cells

Stratified Squamous Epithelium
Epidermis of skin

Stratified Cuboidal Epithelium
Ducts of mammary, Salivary, and Sweat glands

Transitional Epithelium
Urinary bladder,Uterus

Loose (Areolar) Connective Tissue
Beneath epithelium, Covers ventral organs

Adipose Connective Tissue
Beneath skin, Around kidneys, Breasts

Reticular Connective Tissue
Lymph Nodes

Dense Regular Connective Tissue
Tendons, Ligaments

Dense Irregular Connective Tissue
Dermis of skin

Elastic Connective Tissue
Large Blood Vessels (aorta)

Hyaline Cartilage Connective Tissue
Trachea, Articular ends of bones

Elastic Cartilage Connective Tissue
External portion of the ear

Fibrocartilage Connective Tissue
Intervertebral Discs

Bone
Microscopic Structures (osteon, etc.)

Blood

Skeletal Muscle
Striations, Multiple Nuclei

Smooth Muscle
Lacks striations, single nuleus per cell

Cardiac Muscle
Striations visible, Intercalated disks

Nervous Tissue

Skull

bone diagrams












